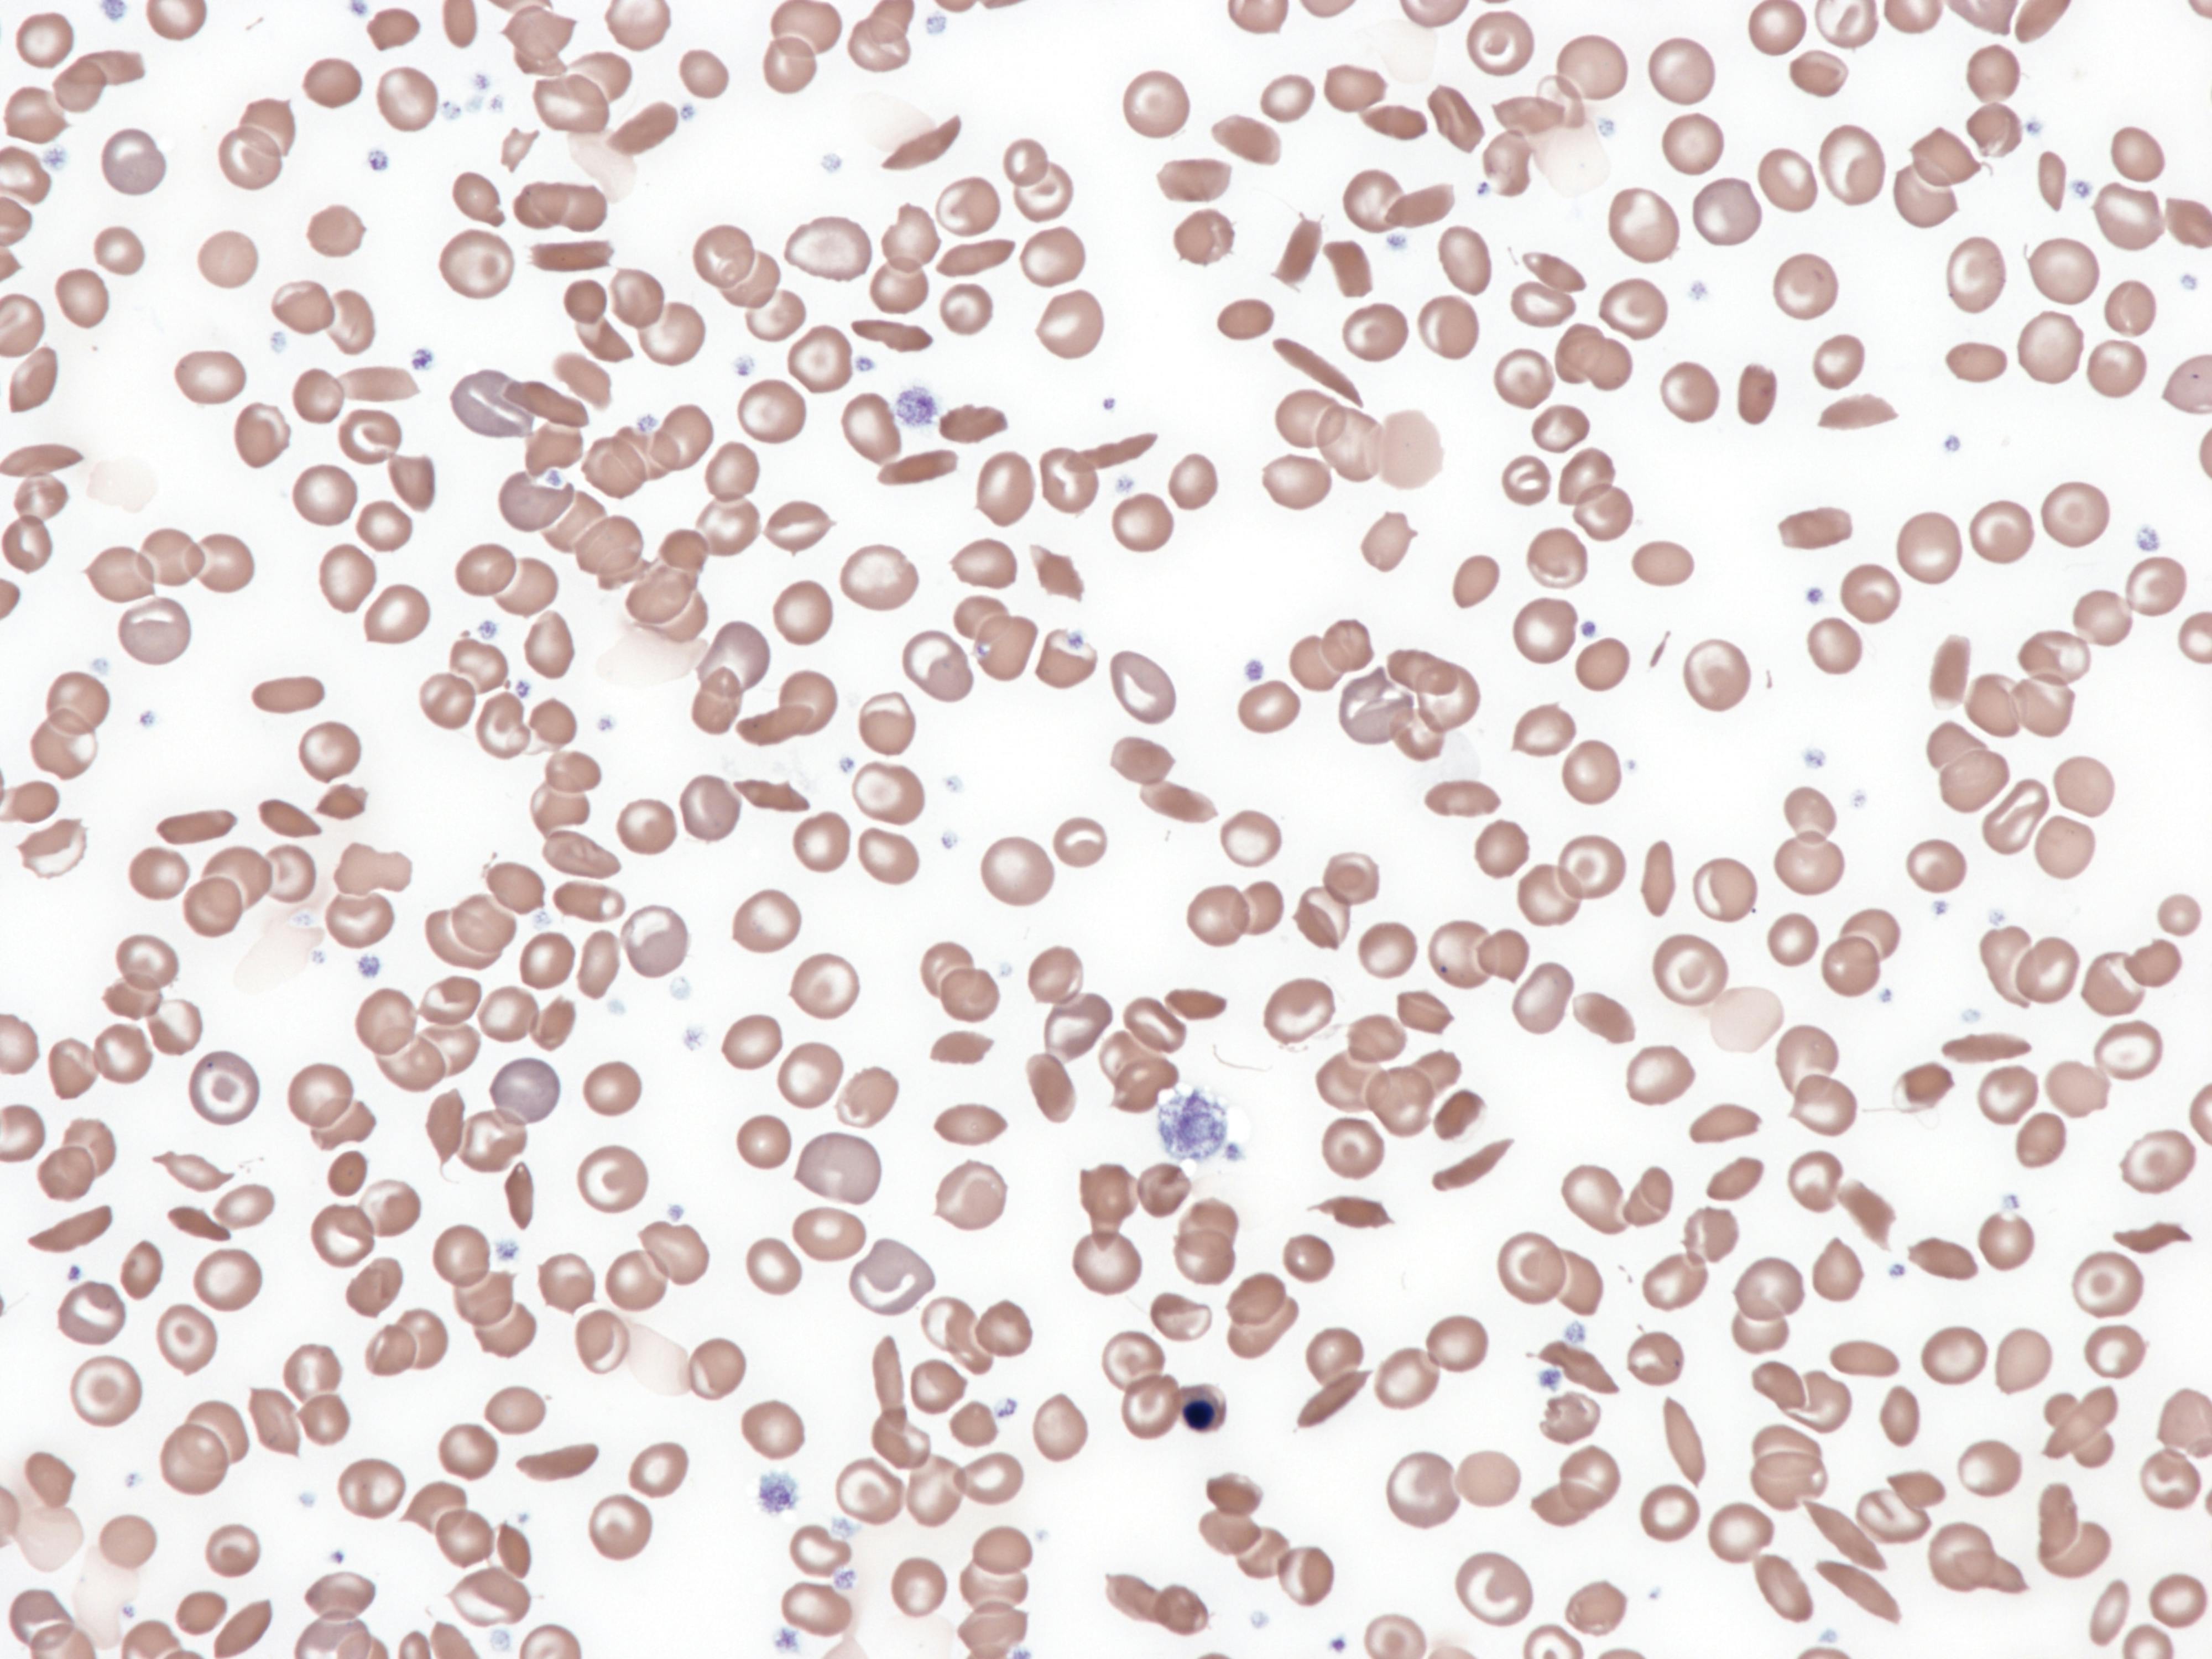
6751c258c99d4d590edf4c6f Dreamstime Xxl 326783302

The Administration announced that two drug manufacturers with Food and Drug Administration-approved gene therapies for sickle cell disease have entered into agreements with the Centers for Medicare & Medicaid Services (CMS) to participate in the Cell and Gene Therapy Access Model.
The voluntary model, led by the Center for Medicare and Medicaid Innovation, will test outcomes-based agreements for cell and gene therapies, with the aim to improve health outcomes, increase access to cell and gene therapies, and lower healthcare costs. These outcomes-based agreements will tie payments to whether the therapy improves health outcomes for people with Medicaid who receive these drugs.
Having secured agreements with the manufacturers of LYFGENIA and CASGEVY, CMS will now move forward with engaging states and U.S. territories that participate in the Medicaid Drug Rebate Program to help them decide whether to participate in the model.
The FDA approved LYFGENIA (lovotibeglogene autotemcel) from bluebird bio, Inc. and CASGEVY (exagamglogene autotemcel) from Vertex Pharmaceuticals, Incorporated in December 2023. CMS negotiated outcomes-based agreements with both manufacturers on behalf of states and will provide states that choose to participate in the model with the technical assistance and data infrastructure to implement these agreements.
The Cell and Gene Therapy Access Model launches in January 2025, and states may choose to begin participation anytime between January 2025 and January 2026. The state application portal goes live this month — December 2024 — and will remain open through February 28, 2025. In addition, states may apply for optional model funding by responding to the notice of funding opportunity, but they are not required to respond to the notice of funding opportunity to participate in the model. The deadline for responding to the notice of funding opportunity is also February 28, 2025.